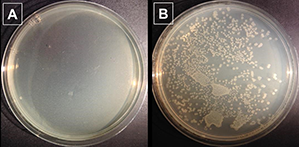
bacterial imaging

The HKUST Library and Publishing Technology Center jointly present

This exhibition features innovative, impactful ideas and projects from the HKUST community in its first 25 years of development. It is composed of over fifty stories in six themes.
Building Capacity, Developing Talents 拓展潛能,培育人才
Providing rich learning experience is the starting point of a university’s journey of transforming lives.
Enhancing Communication Technology 革新通訊科技
Communication technology continues to transform our lives in all aspects.
Innovating Materials 研創新型材料
New materials are the keys to many scientific and technological breakthroughs.
Solving Medical Mysteries 破解醫學之謎
Researches that unlock medical mysteries and find cure can truly transform lives.
Sustaining Environment, Renewing Energy 維護環境,拓新能源
The theme of sustainability is ubiquitous in our daily lives. HKUST researchers contribute to different fronts in the environment and energy realm.
Engaging Society, Nourishing Culture 關心社會,滋養文化
The effort on research and teaching goes beyond the boundary of the University.
HKUST 25th anniversary celebration banquet: innovating today, imagining tomorrow
Providing rich learning experience is the starting point of a university’s journey of transforming lives.Innovative teaching creates opportunities for students’ learning via different means, from e-learning at web platforms, non-traditional design thinking course, experiential service learning, to undergraduate research opportunities. Students are encouraged to take on real-world challenges, via programs such as Hackathon, SIGHT, corporate projects; or competitions such as Robotics team, aircraft design and case competitions.
HKUST reaches out to cultivate talents among secondary school students through the proactive participation in Hong Kong Physics Olympiad and International Mathematical Olympiad.
The Business School takes active steps to train and support students participating in case competitions, which provide an excellent platform for learning how to solve real-world challenges. Locally, the Citi-HKUST International Case Competition has established itself as a signature event in the region. Abroad, our students have taken home multiple international titles.
Video: Citi – HKUST International Case Competition 2015 (Award Presentation)
Video: Citi – HKUST International Case Competition 2015 (Talent Show)
Learn More:
- HKUST MBA Team Wins Prestigious Global Case Competition
- HKUST Undergraduate Team Wins International Case Competition
- HKUST MBA Students Continue Winning Streak in International and Local Case Competitions
- HKUST UG Students Achieve Best Ever Results in International Case Competitions
- HKUST Business Students Win Multiple Professional Institute Competitions
Our students are encouraged to put new ideas into practice. Since 2008, the Business School has collaborated with corporations and organized over 50 corporate projects for undergraduates, where students can contribute their ideas and skills to businesses. These learning activities that the School partnered with well-known international and local companies, such as Ernst & Young, PricewaterhouseCoopers, Ralph Lauren, Savills, TVB, 759 Store are valuable to help students develop necessary skillsets for career development.
HKUST launched Asia’s first MOOC (Massive Open Online Courses) — Science, Technology, and Society in China, in 2013 via Coursera; and Hong Kong’s first credit-bearing MOOC, The Science of Gastronomy in 2014 via edX. Understanding China, 1700-2000: A Data-Analytic Approach pioneered using VisMOOC technology (Clickstream Analysis) to compare the learning behavior of HKUST local students and worldwide learners, using a flipped classroom approach. The 2015 Fall Master of Global Chinese Studies was the 7th semester of HKUST’s MOOC and blended learning initiatives.
Video: Capacity Building in MOOCs and Blended Learning
Learn More:
- HKUST Joins World’s Leading Institutions under edX’s X University Consortium to foster online learning
- HKUST Launches Hong Kong’s First Credit-bearing MOOC and Three New Programs on edX
- HKUST Launches Open Online Courses in Full Stack Web Development on Coursera to Advance Access to Career-Relevant Education
The first ever Hackathon at HKUST was organized and launched in 2014 by a group of student enthusiasts. Building on its first year’s success, the 2015 event, co-organized with the Tencent Foundation, drew over 220 participants from local universities, doubling the 2014 participation rate. What is a Hackathon? Students collaborate intensively on a software or hardware project over 24 hours, aiming to ignite their creativity and entrepreneurial spirit, and turn their boldest ideas into reality. It is also a platform for them to learn from entrepreneurs and industry experts.
The Robotics Team embodies HKUST goals: global outlook and cross-disciplinary work. Since 2004, the team, whose members come from across the globe and both the School of Engineering and the Business School, has won over 70 awards at local, national, and international competitions. It is not just about “winning”. Since 2013, the Team has been in the vanguard of HKUST’s Service Learning, working at different community activities and workshops.
Video: Robotics Team
Display Objects
Learn More:
Coordinated by Student Affairs Office, HKUST Connect aims to provide community engagement and learning opportunities for students through its sustainable partnerships with community organizations, education institutions, and corporations. Students take part in community-based projects, and connect service with their academic skills and experiences. Project groups are facilitated by faculty and staff to enhance the quality of innovative student learning and strengthen participants’ commitment to civic and community development.
SIGHT program, hosted by the Biomedical Engineering Division, empowers undergraduate students to transform passion and creativity into tangible solutions to healthcare problems in resource-limited communities. In 2015 June, the first student members returned to Cambodia with two made-in-HKUST technologies: Electronic Medical Record System, and Drug Dispensary box for a local NGO who runs mobile clinics for the poorest. It has been an experience of lifetime for the students to witness their innovation making a real impact in the world.
Video: SIGHT – Student Innovation for Global Health Technology
The Department of Industrial Engineering and Logistics Management, and the Department of Computer Science and Engineering have collaborated with the prestigious China Academy of Art in Hangzhou on a joint summer course on Design Thinking since 2013. Open to students across both universities, the course fuses design and technology ideas and fosters cross-disciplinary creativity. Starting in Fall 2014, it became a signature course of the new Minor in Design.
Video: Technology Meets Art – IELM Design Thinking Course
HKUST has been organizing the Hong Kong Physics Olympiad for years. The game challenged and nurtured many gifted secondary school students. Winning students are further trained by professors in the Physics Department to take part in the Asian Physics Olympiad, and the International Physics Olympiad. The Hong Kong teams have achieved an outstanding record of gold and silver medals. These medalists continued their outstanding performance at universities. In 2016, HKUST will host the 17th Asian Physics Olympiad.
Talent needs nurture. Partnering with the Hong Kong Education Department, the University in 2001 started to offer Saturday Math classes to young students through the Exceptionally Gifted Students Program. Many of these students participated in the Hong Kong International Math Olympiad (IMO) training program, which was carried out in HKUST every Saturday. These cumulative efforts produced the first Gold medal for Hong Kong in the 2002 IMO.
Pioneered by HKUST, the Undergraduate Research Opportunities Program (UROP) was launched in 2005 to give undergraduate students an early taste of research under faculty guidance. While fostering a research culture within the undergraduate community, UROP encourages students to think critically and to formulate new research problems, with long-term benefit for their careers. Having received enthusiastic support from faculty members and positive feedback from students, it expanded from a summer activity to a signature program offered in all three semesters.
Participating in high-caliber contests is an excellent way for students to grow their ideas, capabilities and confidence. In 2014, five Mechanical and Aerospace Engineering undergraduate students reaped second prize in the first national aircraft design competition organized by the Aviation Industry Corporation of China. The award-winning design “Soaring Dragon” is a 1:10 two-seater amphibious aircraft featuring a pair of hydrofoils at the bottom and a downward folding wing tip.
Video: Winning Team of National Aircraft Design Competition
Communication technology continues to transform our lives in all aspects. Researchers in the School of Engineering explore new possibilities of communication technology. They create real impact by transferring 5G networks technology with major telecommunication corporations; enhancing Wi-Fi performance via LAviNet; and applying wireless connectivity in aircrafts to make flights safer and more enjoyable.
Combining communication technology with robotics, DJI, a start-up by an alumnus, has emerged from HKUST to become a world-leader in the UAV (Unmanned Aerial Vehicles) industry. Another HKUST startup, which originates from developing the world-leading 3D reconstruction technology, is now operating the globally unique UAV 3D reconstruction social platform www.altizure.com.
A first-of-its-kind partnership between Boeing and HKUST bore great fruit. Professors Lionel NI and Qian ZHANG (Computer Science & Engineering) developed in 2007 a wireless communication system which brought revolutionary changes to aircraft maintenance and inflight entertainment. Wi-Fi connectivity enabled seamless communication between cab-in personnel and ground technicians, overriding the cumbersome paper-based scheme in the past. Passengers could also watch movies on demand, play wireless games and use the Internet.
DJI is a recognized world leader in developing and manufacturing high performance Unmanned Aerial Vehicles (UAV) for commercial and consumer use. Founder and CEO Frank WANG is an alumnus in Electrical and Computer Engineering. His mentor, Professor Zexiang LI, played an important role in developing Frank’s knowledge of UAVs and the Robotics industry. Fast Company Magazine ranked DJI alongside Google and Tesla as one of the top 3 most innovative consumer electronics companies in 2015.
Video: DJI Innovations – Leader in Unmanned Aerial Systems
Video: DJI Stories – Above the Flames
Video: DJI Stories – Taking Autism To The Sky
Video: DJI Stories – Crisis Mapping in Nepal
Display Object 10: The 2016 latest model – Phantom 4
LAviNet is based on innovative algorithms to reduce wireless signal interference and network congestion. A ground-breaking technology developed by Professor Gary CHAN (Computer Science & Engineering) in 2011, Lavinet markedly upgrades Wi-Fi network performance. The rate of data flow is more than doubled and signal strength improves by a hundred times.
Professor Vincent Kin-nang LAU (Electronic & Computer Engineering) has contributed to major developments in 5G networks, bringing 1000x higher capacity and new applications, like the Massive MIMO framework, Cloud Radio Access Networks, and the mathematical framework for “cross-layer optimization”. Since joining HKUST in 2004, he has managed technology transfer with companies like TCL and founded the Huawei-HKUST Joint Research Laboratory.
Professor Long QUAN (Computer Science and Engineering) and his research team has developed a comprehensive and the world-leading 3D reconstruction technology and platform which can create next-generation 3D maps from photographs with greater accuracy, higher resolution, and faster speed. A pioneer and world leader in 3D computer vision, Professor Quan plans to map the world in 3D using drone photographs. The cloud map platform altizure.com is on service as a HKUST start-up by some HKUST alumni.
New materials are the keys to many scientific and technological breakthroughs.On the chemical front, AIE polymers can be sensors to detect explosives, bacteria, and to reveal fingerprints; they work much faster than traditional methods. Physicists at HKUST explore superconducting and electrical properties; their projects pave the ways for quantum computing, new MRI technology, and foldable electronic display. On a more theoretical side, research on metamaterials lay the ground for light manipulation and invisibility.
Material research also contributes to innovative building materials. Bendable cementitious composites make concrete structure more durable and provide absorption capability during earthquakes.
AIE has potential applications in many areas. Professor Tang has developed a series of AIE bio-probes which show excellent performance in bacterial imaging and differentiation between living and dead bacteria. Some of the probes can even specifically kill the bacteria under light irradiation. These properties make AIE bio-probes become promising in photodynamic therapy and quality control in food and drug. Other important applications include cancer cells identification. Professor Tang’s work receives international attention and media coverage such as New York Times and CNBC.
Video : Bacterial Imaging
Professor Tang’s research team has further developed a new polymerization method to synthesize a series of polymers whose aggregation-induced emission fluorescence intensity drops dramatically when in contact with some highly nitrated compounds. This makes them sensitive chemosensors for explosive detection – one of the most challenging and important missions for military and customs agencies.
Conventional semiconductor-based computers is approaching their physical limits of computer power and data storage capability. Quantum computing is the new frontier. A research team, led by Professor Iam-keong SOU (Physics), demonstrated a very rare two-dimensional superconductivity at the interface between two new classes of materials Bi2Te3 and FeTe. Their discovery in this emerging field of topological superconductors could lead to the development of practical quantum computers.
Display Object
Collecting and visualizing latent fingerprint is one of the most crucial operations for police to solve crimes. A research team led by Professor Benzhong TANG (Chemistry) has discovered a new fluorescent material Aggregation-Induced Emission (AIE), which could be used to visualize fingerprints more effectively. Fingerprint turns fluorescent when stained with the AIE material, it produces higher quality print when compared to conventional method using carbon powder. It makes evidence collecting 10 times faster.
Professor Che-Ting CHAN (Physics) and his team made major breakthrough in exploring theories with the possibility of rendering materials invisible, using artificial materials that cancel the scattering of light from an object. The team has also designed conceptual devices which can create optical illusions so that an object appears like another pre-specified object.
Video: Rendering Objects Invisible
Professor Che-Ting CHAN (Physics) demonstrated that it is possible to design dielectric photonic crystals as if they had near-zero refractive indices. Light passes through those media with no phase change which means that such zero-index artificial media is optically more “empty” than vacuum which has a refractive index of one.
Video: New Possibilities for Manipulating Light: Making Materials More Empty Than Vacuum
Applications of superconductors have been limited by the low transition temperatures and the need for high critical fields. A research team at HKUST, led by Professor Rolf Walter LORTZ (Physics), achieved a breakthrough in 2013. Using ultrathin lead nanowires, the team demonstrated superconducting properties in a much stronger magnetic field and at higher temperature. One of the benefiting technologies of this development is MRI, which has wide medical applications.
Video: Significant Breakthrough in Superconductivity Using Ultrathin Lead Nanowires for Medical and Biological Applications
Display Object
Like something from a science fiction story, Professor WEN Weijia and his team (Physics) made a new foldable paper-like, thermally activated material for e-display. They fabricated it from thermochromic composite and embedded conductive wiring patterns. It is only 150 microns (0.15mm) thick, but the device can produce high quality color-tunable images controlled via electric heating pulses with reduced energy consumption.
Through years of effort since 1992, Professor Christopher LEUNG (Civil and Environmental Engineering) and collaborators from four other universities in China have developed bendable fiber-reinforced cementitious composites with excellent tensile ductility and crack control. These materials exhibit very high energy absorption capability during earthquakes and ensure the long-term durability of concrete structures under severe environmental conditions.
Video: Bendable Cementitious Materials
Display Object
Researches that unlock medical mysteries and find cure can truly transform lives.Various research teams from the School of Science, through their innovative work on proteins, genes and cells, have shed light on new strategies for treatment of Alzheimer’s disease, neurodevelopmental disorders, blindness, deafness, and muscular diseases.
HKUST has also been active in traditional Chinese medicine research. Among the many results, the Centre for Chinese Medicine developed the technology to extract the key ingredients from herbal recipe Xiasangju to fight flu viruses.
Also in 2011, Professor Mingjie ZHANG’s (Life Science) research team, using a fruit fly photoreceptor as a model system, discovered that a scaffold protein called INAD in animal eyes can undergo a “light-dependent architectural or molecular shape change”. This helps us understand how animal photoreceptors can rapidly detect light signals with broad intensity ranges and how human eyes regulate light intake in response to varying lighting conditions, contributing to research on disorders that cause different types of blindness.
In 2014, Professor Nancy IP and her research team (Life Science) made an exciting discovery – the team identified the protein EphA4 as a key player in Alzheimer’s disease (AD) pathology. They demonstrated that aberrant activation of EphA4 triggers a signaling pathway, which leads to cognitive impairment observed in AD. The team also validated the potential of manipulating this pathway as a possible therapeutic intervention. By blocking EphA4 activity with an EphA4 inhibitor, they showed that cognitive impairment as well as AD pathology was reduced in animal models. These significant findings highlight EphA4 as a new molecular target and offer a novel strategy for AD drug development.
Video: Groundbreaking Discovery Unveils a New Treatment Strategy for Alzheimer’s Disease
In 2012, Professor Zhenguo WU (Life Science) and his research team discovered a novel protein Pax3/7BP, using a series of molecular, cellular, and animal-based assays. Pax3/7BP, along with the protein Pax7 is required for the proliferation of muscle stem cells in young animals, to promote skeletal muscles growth. This breakthrough discovery will facilitate the development of muscle stem cell-based therapies for the treatment of muscle diseases including muscular dystrophies.
In 2011, Professor Mingjie ZHANG (Life Science) and his team used a combination of nuclear magnetic resonance and X-ray crystallography to determine the structure of motor protein myosin VIIa, important for proper development and normal function of human ears and eyes. Genetic mutations of myosin VIIa lead to hereditary deaf-and-blindness. This work is expected to help improve genetic counseling for deaf-and-blind people, and may lead to gene therapy.
Video : Structure of Motor Protein Necessary for Normal Eyesight and Hearing Determined
Can Chinese herbal tea help us fight Avian Flu? Professor Karl TSIM led the Centre for Chinese Medicine R&D (CCM) to develop an advanced technology to extract effective liposoluble ingredients from the traditional Chinese herbal recipe Xiasangju (夏桑菊), which has been found effective in preventing flu virus from entering body cells.
The cerebral cortex is the part of the brain that controls higher mental functions. In 2013, Professor Nancy IP and her research team (Life Science) demonstrated for the first time that growth of the cerebral cortex is regulated by coordinated proliferation and differentiation of intermediate progenitor cells, while disturbances in this precise coordination results in abnormal brain formation. These significant discoveries have enhanced understanding of the evolution of the brain and are providing new insights into the pathophysiology of neurodevelopmental disorders such as autism.
The theme of sustainability is ubiquitous in our daily lives. HKUST researchers contribute to different fronts in the environment and energy realm.Faculty members in the School of Engineering apply technology on sewage treatment and pollution control. Their projects were implemented successfully both locally and overseas. Research teams from both School of Science and School of Engineering make progress in improving solar cells and fuel cells performance that are recognized internationally. High efficiency LED provides energy-saving lighting, while OLED is a power-efficient, quality display technology. To protect us from bacteria, HKUST researchers developed anti-microbial coating for application on a wide range of surfaces, as well as portable device for water disinfection.
To build up the knowledge base for future applications, faculty members in the School of Science study the composition of aerosol, locate the key of photosynthesis, decode the temperature data from the lunar surface, and explore better transportation routes to avoid congestion. One day their research results will contribute to a more sustainable environment for future generations.
Aerosols are tiny particles suspended in the air. Current models do not adequately predict the climatic and health effects of aerosol, partly due to a lack of knowledge about chemical composition of aerosol at the molecular level. In the research led by Professor Jianzhen YU (Chemistry), various advanced analytical techniques are used to identify a myriad diverse organic compounds, significantly expanding our knowledge of aerosol composition. This research is an essential element of a more comprehensive undertaking to understand the climate and health impacts of aerosols.
Video : Aerosol Composition
Where are the valuable resources on the Moon? By analyzing microwave data obtained from China’s first lunar probe, Chang’e-1, Professor Kwing Lam CHAN (Mathematics) studied temperature variations underneath the lunar surface. His findings lay the ground for future lunar landing and exploration for key resources such as titanium, iron, and Helium-3. Professor Chan was invited by the China National Space Administration to join this research in 2007.

Thermal emission of the moon in mid-night (no sun light); peculiar cold spots (A-E) were discovered the first time
Learn More
The SANI (Sulphate reduction, Autotrophic denitrification and Nitrification Integrated) Process is a novel sewage treatment technology developed by Professor Guanghao CHEN (Civil and Environmental Engineering). Since 2013, a large-scale trial of SANI technology has been successfully implemented at Shatin Sewage Treatment Works at a capacity of 1,000 cubic meters a day. 2014 was another milestone year; UNESCO-IHE Institute of Water Education partnered with HKUST on a three-year water-saving project “AGUA PARA TODOS” (More Water for All) in Cuba using SANI, which is proved to be one of the most economical and energy efficient ways for water saving in islands and coastal cities.
Video: SANI Demonstration Plant
Video: Eco-Friendly Sewage Treatment
Learn More
- HKUST Invents a Novel Sewage Treatment Technology – The ‘SANI’ Process Minimizing 50% Cost and 90% Sewage Sludge Production
- HKUST Kicks off Hong Kong’s Novel Sewage Treatment Technology Trial Run Securing the Biggest Sponsorship with Five International Awards
- HKUST and UNESCO-IHE Partnership to Apply HKUST-developed Sewage Treatment Technologies to tackle Water Scarcity in Cuba
HKUST scientists aim to make dependence on fossil fuels a thing of the past. Professor Tianshou ZHAO (Mechanical and Aerospace Engineering) and his team achieved a major breakthrough in their research on the physical and chemical reaction of fuel cell in 2014. They successfully improved the performance of Direct Methanol Fuel Cells (DMFC) and Direct Ethanol Fuel Cells (DEFC) by six times and four times respectively. It paved the way to further develop fuel cells as a clean, efficient, scalable and sustainable energy production technology.
Video: High Performance Alcohol Fuel Cell
In 2014, Professor He YAN’s research team (Chemistry) discovered a material design motif leading to multiple high-performance material combinations. Most recently, a new record of 11.5% efficiency organic solar cells by the group was noted as a major technology breakthrough in the “best research-cell efficiencies” chart by NREL, the first time that Hong Kong has appeared on this renowned solar cell chart.
Video: New Materials for Solar Cells with Record-Breaking Efficiency
Display Object
In 2014, a research team led by Professor King Lun YEUNG (Chemical and Biomolecular Engineering) and Professor Joseph KWAN (Environment) invented a mini-pulsed electric field which could kill over 99% of bacteria in tap and raw water preventing transmission of diseases. It is portable, battery powered that can be installed at home and any public water supplies.
Video: Mini Pulsed Electric Field Device for Water Disinfection
Display Object
In 2006, MTR collaborated with HKUST and trial launched using High Brightness LED Solid State Lighting (SSL) modules for saloon lighting in one train carriage on the Tsuen Wan Line. After 2 years of successful operation, MTR extended installation to 24 carriages, as well as to the stations. This cutting-edge technology produced brighter lighting, consumed less energy and substantially reduced maintenance cost and waste disposal.
The research team of Professor King Lun YEUNG (Chemical and Biomolecular Engineering) and Professor Joseph KWAN (Environment) developed a smart anti-microbial coating that can be applied on surfaces from glass to cloth. Transparent, colorless, odorless, and effective for at least 30 days, it can kill 99.9% of bacteria within one minute, 99% of H1N1 virus in three minutes, 99% of bacillus spores in 30 minutes, and inhibits mold and fungal growth.
Video: New Weapon Unveiled in Fight Against Infection
Display Object
Professor Ching Wan TANG (Electronic and Computer Engineering) invented the organic light emitting diode (OLED), which is now widely adopted in a wide range of display applications such as mobile phones, digital cameras and large-screen televisions. OLED delivers power-efficient thin and light displays with ultra-high definition and wide viewing angle. Professor Tang won the prestigious 2011 Wolf Prize in Chemistry.
In 2014, Professor Xuhui HUANG and Professor Yijing YAN’s team (Chemistry) solved a long-standing puzzle in photosynthesis: why only ½ the pigments in Photosystem II protein’s reaction center actively participate in electron transfer and oxygen production. They found the dynamic and asymmetric protein environment makes chlorophyll CLA606 more easily activated by sunlight. Their results provide insight into the design of artificial photosynthetic systems that may lead to new solar energy devices.
Video: Photosynthesis Puzzle Solved – Insights for Future Solar Devices
Display Object
In 2013, Dr. Chi-ho YEUNG and Prof. Michael WONG (Physics) in collaboration with Prof. David SAAD (Aston University) applied polymer physics to find a new way to coordinate routes that avoid rush-hour crowding. Using data from the London Underground, their simulations reduced passenger crowding by 24%, while the trips took only an average of 5% longer.
Devoted to environmental research into contamination and pollution control, Professor Irene LO (Civil and Environmental Engineering) works with governments across the world on environmental problems. In 2000, she partnered with the Danish government to clean up highly polluted groundwater in Vapokon. More recently, she has worked with Guangdong Province on remediating river sediments; while her research into synthesizing magnetic nanomaterials to remove heavy metals for wastewater treatment has led to new patents in China.
Video: Soil, Sediment and Water Pollution Control
The effort on research and teaching goes beyond the boundary of the University. The Business School has established an excellent international reputation for its programs. It persistently enhances relationships with local and global business communities, and engages leaders from there. Business students transform their academic skills to make real differences in local organizations by participating in projects on social responsibilities and business ethics service. As an effort to develop leaders, the Leadership and Public Policy Executive Education program inspires over a thousand participants for better policy-making and decisions in various sectors.
The scholars in the School of Humanities and Social Sciences help us to rediscover the cultural heritage in Hong Kong, and to understand social dynamics through a number of research projects. At the same time, they create innovative platforms and programs for the university community to experience a diversity of music, fine arts, and literature via creative arts education.
Today’s business world becomes more transparent, and thus sees a growing demand for graduates who are educated with business ethics. Since 2012, the Applied Ethics Service Project of the Business School has launched to encourage students to participate in small group-based service projects, with ideas for these projects that come from themselves. Students make connections between ethical concepts and actual situations in Hong Kong that relate to a wide range of business, social and environmental topics.
The Business School has established an excellent international reputation for its postgraduate degree programs – and its undergraduate degrees are renowned for their innovations and ability to motivate students aspiring to global leadership. The Kellogg-HKUST Executive MBA program has been ranked #1 globally six times in the past nine years by the Financial Times, and the HKUST MBA program has been ranked #1 in Asia six times in the past seven years.
Led by the School of Humanities and Social Science, the creative arts education initiative seeks a new understanding of creativity by focusing on contemporary music and literature. Hailed as “the city’s most innovative musical experience” by Financial Times, The Intimacy of Creativity brings together composers and performers to explore the creative process. Literature and creative writing brings contemporary writers-in-residence to speak and recite their work. Many of the invited writers are world-renowned, including GAO Xingjian and YAN Lianke.
Video: Intimacy of Creativity 2012
The Leadership and Public Policy Executive Education (LAPP), developed by Professor Angelina YEE and her team, has been contributing to development of globally minded leaders in government, corporate and nonprofit sectors. Through this platform of intellectual exchange on public policy issues, over a thousand participants have deepened and broadened their perspectives for better policy-making and decisions in various sectors.
Learn More
- Oxford and HKUST Sign MoU in Davos on Establishing a Leadership and Public Policy Series
- HKUST and University of Oxford Launch Leadership and Public Policy Program to Enhance Senior Executive Education and Foster Social and Economic Development
- HKUST Leadership and Public Policy Forum to Discuss the Way Forward for Democracy in Hong Kong
The South China Research Center at HKUST makes major contribution to our awareness and understanding of Hong Kong folk culture. In 2009, the government commissioned the Center to conduct a territory-wide cultural survey, completed in 2013. The 480 items in The First Intangible Cultural Heritage Inventory of Hong Kong showcase the traditions that make Hong Kong unique. Some, including the Tai O Dragon Boat Water Parade, were reestablished through this increased visibility.
Video: Living Heritage of Hong Kong
Chinese Higher Education – 50 Years of Social Inclusion
At HKUST, our students, like undergraduates at other Hong Kong and mainland universities come from society as a whole. This is in contrast to places like the United States, where university students generally come from better-off families. Professor James LEE (Social Science) and his team found this via a quantitative study of hundreds of thousands of student records from Chinese universities from 1952-2003. China’s college entrance examination may have played a role in objective selection, enabling a broad range of social inclusion in higher education during this period.
Hong Kong Panel Study of Social Dynamics (HKPSSD), the first-ever household panel study in the city, surveyed 8,100 adults/children from 3,214 households in 2011, and interviewed them in 2013 and 2015, to track social and economic changes and their impacts on individuals in the city. Led by Professor Xiaogang WU (Social Science), HKPSSD provides an important data source for the study of people’s livelihood issues and evidence-based policy in Hong Kong.
The Business School shows genuine concern for the communities. Since 2007, the Business School has organized over 50 Social Responsibility Projects in collaboration with around 40 organizations such as the Hong Kong Federation of Youth Groups and the Hong Kong Christian Service and Regeneration Society. These projects encourage students to extend their care to the underprivileged. Meanwhile, the School pioneered the Social Entrepreneurship and Venture Philanthropy Course in 2013 with the support of the Yeh Family Philanthropy, in which teams of students bid for a grant on behalf of partnered social enterprises to bring positive impact.
Video: Dress Habitat Day
The Business School continues to enhance relationships with business communities locally and globally. Its School Advisory Council consists of top global business leaders providing strategic advice and support on future developments. The Business School also features distinguished business leaders from around the globe to speak to the HKUST family and communities at large.
Video: HKUST 25th Anniversary Distinguished Speakers Series – Debt and Capitalism Dr Raghuram Govind Rajan, Governor of the Reserve Bank of India
Video: FSDC Practitioner Speakers Series – Careers in Financial Services Mr Andrew Butcher, Senior Country Officer for Hong Kong at J.P. Morgan
Video: Asian Leadership Series – Mr. Kenneth W. Hitchner, President of Goldman Sachs in Asia Pacific Ex-Japan
“Silk Road of Calligraphy” is a 1-HKUST Life Award supported event, initiated by the Mainland Students and Scholars Society (MSSS) and supported by the HKUST Students Union, the HKUSTSU Chinese Orchestra, as well as the HKUSTSU Arts Club. Faculty members and students from many backgrounds collaborated to create this artwork, a 5-meter long scroll of calligraphy.
As the Silk Road of ancient times connected China with other nations across Asia and Europe, so too does this event, like the ancient Silk Road, serves as a bridge between faculty members and students to promote a 1-HKUST spirit for the whole HKUST community.
Scroll calligraphy is a traditional Chinese form of artistic expression, and such scrolls are often displayed for public appreciation. This work, painted by professors and students together, celebrates the past 25 years of great accomplishments and expresses their best wishes for HKUST’s continued good fortune.
We are grateful to HKUST Library for its support and help.
HKUSTSU Mainland Students and Scholars Society

3:30 pm
(The opening ceremony will be followed by a tea reception)
Ping Yuan and Kinmay W Tang Gallery
English
Officiating Guests
Prof Tony F Chan, President, HKUST
Prof Nancy Ip, Dean of Science, HKUST
Prof James Lee, Dean of Humanities & Social Science, HKUST
Prof Tongxi Yu, Acting Dean of Engineering, HKUST
Prof Emily Nason, Associate Dean of Business and Management, HKUST
Ms Diana Chan, University Librarian, HKUST
Mr Thomas Ng, Director of Publishing Technology Center, HKUST

We are glad to work with academic departments and units to organize guided tours of the current exhibition: Transforming Lives: An Exhibition for HKUST 25th Anniversary.
The Tours
- Audience: guests and visitors to HKUST
- Group size: up to 20
- Length: 15-20 minutes
- Location: Library Gallery
- Tour guides: students (arranged by the Library or the collaborating unit), or Library staff
Student tour guides assigned by the Library receive training in advance. If a collaborating unit prefers to have guides arranged otherwise, we can provide a brief information sheet of the exhibition for the guides.
Contact Mr. Edwin Leung (x6708; lbwaikei@ust.hk) for details.
Transforming Lives: A library Exhibition for the 25th Anniversary
(Issue No. 100, April 2016)

In its first 25 years, the HKUST community brought about many innovative ideas in teaching, research, and society engagement. To celebrate the 25th Anniversary of the University, the Library has organized an exhibition featuring a selection of these impactful ideas and projects.
Entitled “Transforming Lives”, the exhibition is running from April to December. It contains over fifty stories grouped under six themes:
1. Building Capacity, Developing Talents
The University explores a variety of teaching modes and learning experiences for students. This theme highlights twelve stories on non-traditional teaching and experiential learning.
2. Enhancing Communication Technology
HKUST researchers make numerous contributions in communication technology. The theme covers five projects from IT infrastructure such as 5G networking technology, to applications including wireless connectivity and aerial photography.
3. Innovating Materials
New materials are the key to many scientific and technological breakthroughs. Research projects in chemistry and physics as well as material science at HKUST have been making advances in both theory and application. You will find nine different research stories in this theme.
4. Solving Medical Mysteries
Researches that unlock medical mysteries and find cures can truly transform lives. Various research teams at HKUST explore new strategies for treatment of diseases via advances in neurology, cell biology, and traditional Chinese medicine. Six projects are highlighted in this theme.
5. Sustaining Environment, Renewing Energy
In the theme of sustainability you can find twelve stories of HKUST researchers contributing to different fronts. There are projects on sewage treatment, pollution control, energy efficiency, display technology, and other environmental areas.
6. Engaging Society, Nourishing Culture
One of the missions of HKUST is to assist in the economic and social development of Hong Kong. In 25 years, the University engages business communities and develops social leaders. We also contribute to a better understanding of our cultural heritage and social dynamics; and enhance creative arts education via different programs. Nine stories unfold in this theme.
- I like the badminton robot , so far , great job !
- 我好鍾意羽毛球機械人 , 希望有一日可以同佢較量.
- 科技大學有非一般的科技。
- So proud of Dr.Irene Lo on her global achievement !
- Nice invention . All are a great idea !
- 科技大學有非一般的科技 .
- 我已經被這些化學實驗震撼了!
- 你們的機器很好
- I liked the Phantom 4. I hope I can have one.
- 哈利波特的隱形斗篷真有新意
- Actually all the works are excellent
- The robots are fantastic!
- 科技是沒有國界的,但科學家是有國界的,科技強國!
- Good robots! I like them!
- I like the pictures. It is funny
- Exceptionally good work!!
Ping Yuan and Kinmay W Tang Gallery